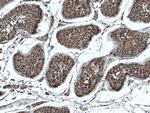
FKBP3 Antibody in Immunohistochemistry (Paraffin) (IHC (P))

Search
Proteintech
FKBP3 Polyclonal Antibody
{{$productOrderCtrl.translations['antibody.pdp.commerceCard.promotion.promotions']}}
{{$productOrderCtrl.translations['antibody.pdp.commerceCard.promotion.viewpromo']}}
{{$productOrderCtrl.translations['antibody.pdp.commerceCard.promotion.promocode']}}: {{promo.promoCode}} {{promo.promoTitle}} {{promo.promoDescription}}. {{$productOrderCtrl.translations['antibody.pdp.commerceCard.promotion.learnmore']}}
产品信息
11755-1-AP
种属反应
宿主/亚型
分类
类型
抗原
偶联物
形式
浓度
规格
纯化类型
保存液
内含物
保存条件
运输条件
产品详细信息
Immunogen sequence: MAAAVPQRA WTVEQLRSEQ LPKKDIIKFL QEHGSDSFLA EHKLLGNIKN VAKTANKDHL VTAYNHLFET KRFKGTESIS KVSEQVKNVK LNEDKPKETK SEETLDEGPP KYTKSVLKKG DKTNFPKKGD VVHCWYTGTL QDGTVFDTNI QTSAKKKKNA KPLSFKVGVG KVIRGWDEAL LTMSKGEKAR LEIEPEWAYG KKGQPDAKIP PNAKLTFEVE LVDID (1-224 aa encoded by BC020809)
靶标信息
The protein encoded by this gene is a member of the immunophilin protein family, which play a role in immunoregulation and basic cellular processes involving protein folding and trafficking. This encoded protein is a cis-trans prolyl isomerase that binds the immunosuppressants FK506 and rapamycin, as well as histone deacetylases, the transcription factor YY1, casein kinase II, and nucleolin. It has a higher affinity for rapamycin than for FK506 and thus may be an important target molecule for immunosuppression by rapamycin.
仅用于科研。不用于诊断过程。未经明确授权不得转售。
生物信息学
蛋白别名: 25 kDa FK506-binding protein; 25 kDa FKBP; FK506 binding protein 3, 25kDa; FK506-binding protein 25, T-cell; FK506-binding protein 3; FK506-binding protein 3 (25kD); FKBP-25; FKBP-3; Immunophilin FKBP25; Peptidyl-prolyl cis-trans isomerase FKBP3; PPIase FKBP3; rapamycin binding protein; Rapamycin-selective 25 kDa immunophilin; Rotamase; unnamed protein product
基因别名: 25kDa; FKBP-25; FKBP-3; FKBP25; FKBP3; PPIase
UniProt ID: (Human) Q00688, (Mouse) Q62446
Entrez Gene ID: (Human) 2287, (Mouse) 30795, (Rat) 299104